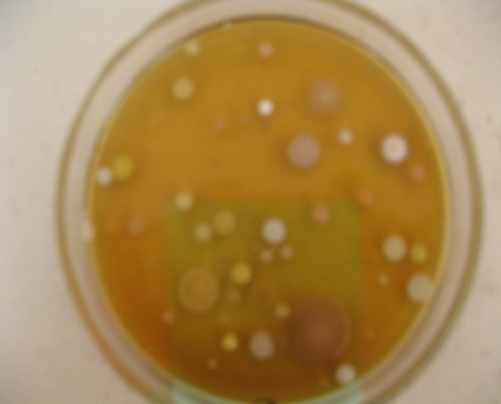
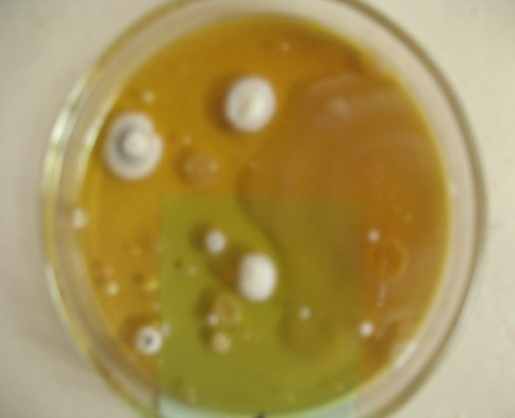

Детская Творческая Олимпиада kidolimp Естественные науки исследовательская работа
Вид материала | Исследовательская работа |
Содержание2.2. Инфекции, передающиеся воздушно-капельным путём Возбудители дифтерии Патогенные кокки |
- Детская Творческая Олимпиада kidolimp Поэтическое искусство, 8.47kb.
- Детская Творческая Олимпиада kidolimp проза сон Деда Мороза (сказка), 64.04kb.
- Детская Творческая Олимпиада kidolimp художествнееая проза сказка, 15.62kb.
- Детская Творческая Олимпиада kidolimp художественная проза сказка, 6.52kb.
- Детская Творческая Олимпиада kidolimp Художественная проза рассказ, 13.81kb.
- Детская Творческая Олимпиада kidolimp Художественная проза сказка, 22.54kb.
- Творческая деятельность, 1688.28kb.
- Конкурс Руководитель Павлова Евгения 4 в Диплом лауреата второй степени Международная, 22.98kb.
- Творческая работа Окристаллах, 182.71kb.
- Естественные науки в целом в физико-математические науки разделы "В2 Механика", "В3, 721.35kb.
Детская Творческая Олимпиада kidolimp
Естественные науки
Исследовательская работа
Микрофлора воздуха
Автор: ученица 11 класса
Браташова Т., 16 лет
Астраханская область,
г. Астрахань
Оглавление
Введение…………………………………..…………………………..…..………3
Глава 1
Обзор литературы по данной теме………………….............. …………….......4
Глава 2
2.1.Микрофлора воздуха, ее качественный и количественный состав……….5
2.2. Инфекции, передающиеся воздушно-капельным путём………………….6
2.3. Санитарно-гигиеническое состояние воздуха помещений ……………….9
Глава 3
3.1. Санитарно-микробиологическое исследование воздуха…………………..11
3.2. Методика исследования……………………………………………………....12
3.3. Результаты исследования………………………………………………….….12
Заключение……………..…………………………………………………….........17
Список использованной литературы…….....................…….……………… .....19
Приложение………………………………………….............................................20
Введение
Атмосферный воздух один из главных источников жизни на земле. Земную атмосферу составляет естественная смесь газов, главным образом азота и кислорода. Под действием воздуха и воды совершаются важнейшие геологические процессы на поверхности Земли. Воздух является источником кислорода, необходимого для нормального существования подавляющего числа живых организмов, а для жизни микроорганизмов является неблагоприятной средой. В нем они не находят пищи, подвергаются высушиванию, губительному действию прямых солнечных лучей и поэтому большая часть их погибает.
Состав микробов воздуха весьма разнообразен. Он зависит от степени загрязнения воздуха минеральными и органическими взвесями, температуры, осадков и др. факторов. Чем выше концентрация в воздухе пыли, тем больше микробов. Существует мнение, что микробы воздуха переносятся с током воздуха, неразмножаясь, хотя это мнение и оспаривается.
В пыльном воздухе помещения микробов может быть тысячи в 1 куб.м воздуха.
Одним из основных объектов исследования при подготовке характеристики экологического состояния помещений является микрофлора воздуха.
Можно ли доказать наличие микробов в воздухе и подсчитать их количество? Этот вопрос нас заинтересовал, и мы поставили перед собой цель: определить количество микробов в определенном объеме воздуха в кабинете биологии, провести статистическую обработку полученных данных, в разное время года, сделать описание выросших колоний бактерий и выявить факторы, влияющие на микробную обсеменённость помещений.
В связи с этим я поставила перед собой следующие задачи
- ознакомиться с литературой по микрофлоре воздуха;
- изучить метод Коха, позволяющий подсчитать количество микробов в определенном объеме воздуха;
- ознакомиться с признаками описаний колоний бактерий;
-сравнить КОЕ в м³ воздуха в кабинете биологии на различных уровнях;
- подсчитать микробное число в кабинете биологии в разное время года;
- выявить зависимость чистоты воздуха в кабинете биологии от выполнения санитарно- гигиенического режима, используя метод Коха.
Таким образом, объектом моего исследования является кабинет биологии, а предметом - микрофлора воздуха. В ходе выполнения исследования мною использованы такие методы, как изучение справочной литературы по микробиологии и медицине; обработка статистических данных; анализ собранной информации; построение таблиц, описывающих микрофлору воздуха кабинета биологии, фотографирование результатов исследования.
Глава 1
Обзор литературы по данной теме
В ходе исследования мною была проанализирована научно-популярная литература: С.А.Блинкин «Вторжение в тайны невидимок», в которой рассказывается о том, как человек борется с вредными микробами и использует полезную деятельность микроскопических друзей; справочник по микробиологическим и вирусологическим методам исследования под редакцией М.О.Биргера; «Основы микробиологии, санитарии и гигиены в пищевой промышленности» Жвирбляной А.Ю., Бакушинской О.А.. Это пособие для студентов пищевой промышленности знакомит нас с основами микробиологии, санитарии. Методическое пособие для студентов «Микрофлора воздуха» (составитель Куликова И.Ю), дает описание качественного и количественного состава воздушной микрофлоры, описывает метод Коха, позволяющий подсчитать количество микробов в определенном объеме воздуха, перечисляет признаки, по которым можно описать колонии бактерий.
Также мною были изучены ресурсы интернета: «Микрофлора воздуха жилых помещений» (2009); g.ru/lib/children/ - 17k - . ссылка скрыта n.allbest.ru/ecology/00019711_0.php - 144k -.
Данный список литературы мне показался достаточным, для того чтобы начать собственное исследование «Микрофлоры воздуха».
Глава 2
2.1.Микрофлора воздуха, ее качественный и количественный состав
Количественный и качественный состав микрофлоры воздуха зависит от степени загрязнения его пылью, копотью, дымом и другими минеральными и органическими взвесями. Её видовой и количественный состав зависит от микрофлоры территории, над которой исследуется воздух.
Одним из первых исследователей, установивших наличие значительного числа бактерий в воздухе, был Луи Пастер. Его опыты показали, что воздух помещений содержит значительное число бактерий и что, наоборот, их мало в воздухе над высокими горами.1
Чисто условно микрофлору воздуха можно разделить на постоянную, т.е. более часто обнаруживаемую в воздухе, и переменную, находящуюся в воздухе не всегда и менее стойкую к воздействию различных факторов окружающей среды. К постоянной микрофлоре, формирующейся за счет микроорганизмов почвы, относятся различные пигментообразующие кокки, палочки, спорообразующие бациллы, актиномицеты, грибы и др.
Бактериальная зараженность закрытых помещений (жилых комнат, общественных помещений) всегда большая, особенно зимой, чем зараженность наружного воздуха. Объясняется это тем, что зимой человек проводит большую часть времени в помещениях, уборка и вентиляция которых не всегда соответствуют санитарно-техническим нормативам.
Микрофлора воздуха помещений зависит от их санитарно-гигиенического режима - размеров помещений, условий освещенности, качества уборки, частоты проветривания и других факторов. На загрязнение воздуха помещений пылью и соответственно микроорганизмами существенное влияние оказывает количество находящихся в нем людей и род их деятельности. При скоплении людей, плохой вентиляции, слабом естественном освещении, неправильной уборке помещений количество микробов увеличивается. Сухая уборка, редкое мытье полов, использование грязных тряпок и щеток, сушка их в том же помещении создают благоприятные условия для накопления в воздухе микробов. В закрытых помещениях микрофлора более обильна зимой, меньше -летом, что обуславливается большей возможностью проветривать комнаты.
Большинство микробов, содержащихся в воздухе, относятся к сапрофитам. Однако в нем могут находиться и патогенные для людей, животных и растений виды: туберкулезная палочка, стрептококки, стафилококки, возбудители гриппа, коклюша и так далее. Гриппом, корью, коклюшем заражаются исключительно капельно-воздушным путем. При кашле, чихании выбрасываются в воздух мельчайшие капельки-аэрозоли, содержащие возбудителей заболеваний, которые вдыхают другие люди и, заразившись, заболевают. Они попадают в воздух вместе с выдыхаемым воздухом в виде аэрозолей, с выделениями больных людей и животных, разносятся ветром с больных растений или их остатков.
2.2. Инфекции, передающиеся воздушно-капельным путём2
Микобактерии туберкулёза. Микобактерии туберкулёза были открыты Р. Кохом в 1882 г. По сравнению с другими неспорообразующими палочками микобактерии туберкулёза очень устойчивы во внешней среде. В проточной воде они могут сохраняться до 1 года, в почве и навозе — 6 мес., на различных предметах — до 3 мес. Микобактерии чувствительны к солнечному свету. Заболевание туберкулёзом распространено повсеместно. Источником инфекции является больной человек. Ежегодно от туберкулёза умирают 3 млн. человек. Инкубационный период при туберкулёзе сравнительно продолжительный — от нескольких недель до 5 лет. Туберкулёз характеризуется многообразием клинических форм. Профилактика туберкулёза обеспечивается путём ранней диагностики, своевременного выявления больных и их диспансеризации.

Возбудители дифтерии. Корнебактерии дифтерии — это прямые или слегка изогнутые палочки. Спор не образуют, жгутиков не имеют, имеют микрокапсулу. Возбудители дифтерии достаточно устойчивы к различным факторам внешней среды. При комнатной температуре на различных предметах могут сохраняться от 1 до 2 месяцев. Наиболее восприимчивы к дифтерии дети от 1 до 7 лет. Заболевания начинается с повышения температуры тела, боли при глотании, появлении плёнки на миндалинах. Профилактика обеспечивается путём ранней диагностики, своевременного выявления больных и их госпитализации, а также прививки.

Коклюш. Возбудители коклюша — мелкие палочки овальной формы. Во внешней среде не устойчивы. На солнечном свету погибают через час. Заражение коклюшем происходит через дыхательные пути. При коклюше у больного появляются приступы спазматического кашля, доводящего до рвоты, посинения, остановки дыхания. Таких приступов может быть 5-4 в сутки.

Патогенные кокки
Стафилококки. В этой обширной группе микроорганизмов встречаются как сапрофиты, обитающие в окружающей среде, так и патогенные виды. Стафилококки — это небольшие круглые клетки, после деления располагаются в мазках одиночно, парами или в виде гроздьев винограда. Стафилококки являются нормальными обитателями кожи и слизистых оболочек человека. Всего известно 30 видов этих микроорганизмов. Типовой патогенный вид — золотистый стафилококк. Известно более 100 клинических форм проявлений стафилококковых инфекций. Стафилококки способны поражать практически любые ткани и органы. Среди патогенных микроорганизмов стафилококки наиболее устойчивы в окружающей среде. Они хорошо переносят высушивание, замораживание. Прямой солнечный свет убивает стафилококки в течение нескольких часов.

Стрептококки. Этот род представлен более 20 видами бактерий, среди которых встречаются как патогенные, так и представители нормальной микрофлоры человека. Стрептококки — это мелкие шаровидные клетки, в мазках располагаются парами или цепочками. В окружающей среде — в пыли, на различных предметах сохраняются долго. Основным механизмом передачи стрептококковой инфекции является контактно-бытовой. Также возбудители могут передаваться воздушно-капельным путём. Стрептококки вызывают у человека многие болезни: скарлатину (заражение происходит воздушно-капельным путём, характеризуется появление высыпаний на шее и верхней части грудной клетки), ангину, ревматизм и др.

Мениногококки. Возбудители менингококковой инфекции — мелкие диплококки, в мазках напоминают кофейные зёрна. Во внешней среде быстро погибает. Основной источник менингококковой инфекции больной человек, возбудитель передаётся воздушно-капельным путём. Менингит начинается остро. Отмечается высокая температура, рвота, судороги, очень сильная головная боль.

2.3 Санитарно-гигиеническое состояние воздуха помещений
Ультрафиолетовые лучи весьма губительны для микроорганизмов, но если последние адсорбированы на частицах пыли или других веществ, то оказываются надежно защищенными от действия ультрафиолетового облучения.
Качественный состав микрофлоры воздуха нестабилен и в значительной мере зависит от местных источников загрязнения. Микрофлора воздуха весьма динамична и подвергается непрерывному обновлению.
Чисто условно микрофлору воздуха можно разделить на постоянную, т.е. более часто обнаруживаемую в воздухе, и переменную, находящуюся в воздухе не всегда и менее стойкую к воздействию различных факторов окружающей среды. К постоянной микрофлоре, формирующейся за счет микроорганизмов почвы, относятся различные пигментообразующие кокки, палочки, спорообразующие бациллы, актиномицеты, грибы, дрожжеподобные грибы и др. Наиболее часто из воздуха выделяются Micrococcus roseus. M. Flavus.
Санитарно-гигиеническое состояние воздуха помещений определяется двумя показателями: микробным числом – содержанием общего числа микроорганизмов в 1 куб. м воздуха; числом санитарно-показательных бактерий – гемолитических стрептококков и стафилококков в 1 куб. м воздуха ( табл.1).
Таблица 1 Критерии оценки микробной загрязненности воздуха
Пробы воздуха | Сезон года | Микробное число | Число гемолитических стрептококков в 1 куб. м воздуха |
Атмосферный воздух зеленой зоны | Среднегодовые | До 350 | |
Жилое невентилируемое помещение А) чистый Б) загрязненный | Летом « « | До 1500 Более 2500 | До 16 Более 36 |
А) чистый | Зимой « | До 4500 | До 36 |
Б) загрязненный | « | Более 7000 | Более 124 |
Но эти критерии оценки загрязненности воздуха ориентировочные, так как узаконенных нормативов по бактериальной обсемененности воздуха закрытых помещений для оценки чистоты в настоящее время не существует.9
В тех случаях, когда в воздухе помещений обнаруживаются патогенные микроорганизмы, воздух считается загрязненным и эпидемически опасным.
Бактериальная обсемененность жилых помещений всегда превышает обсемененность атмосферного воздуха, в том числе и патогенными микроорганизмами, попадающими в воздух от больных людей, животных и бактерионосителей.
Глава 3
3.1.Санитарно-микробиологическое исследование воздуха
Задачами санитарно-микробиологического исследования воздуха являются гигиеническая и эпидемиологическая оценка воздушной среды, а также разработка комплекса мероприятий, направленных на профилактику аэрогенной передачи возбудителей инфекционных болезней.
Санитарно-микробиологическое исследования воздуха проводят в основном по двум направлениям:
- определение микробного числа воздуха, т.е. количества микроорганизмов, находящихся в 1 куб.м воздуха.
- Исследование воздуха на наличие санитарно-показательных микроорганизмов, которые являются показателями биологической контаминации воздуха микрофлорой носоглотки человека.
Объектами санитарно-микробиологического исследования воздуха является: воздух больниц, детских садов, школ, аптек, а также мест массового скопления людей.10
Для обнаружения микробов в воздухе предложено большое количество методов и приборов, позволяющих определять как общее количество, так и видовой состав микрофлоры. Определение количественного состава и качественного состава микрофлоры воздуха проводится методами, в основу которых положены два принципа: оседание и засасывание.
Отбор проб осуществляется различными приборами и способами. Наибольшее применение нашли чашечный метод Коха, фильтрация через желатиновые пенистые фильтры, прибор Киктенко.
3.2 Методика исследования
Для определения количества КОЕ в воздухе используют простой метод Коха ( осаждение клеток микроорганизмов на плотных питательных средах). Суть его сводится к следующему. Стерильные чашки Петри с питательной средой (МПА) открывают в исследуемом помещении на 5 мин. Частицы пыли с бактериями под действием силы тяжести оседают на поверхность плотной питательной среды. На 5-е утки инкубации при 28-30 С осевшие бактерии образуют на среде колонии, которые можно подсчитать.
На площади в 100 см2 за 5 мин осаждается примерно столько клеток, сколько их находится в 10 л воздуха (0, 01 куб.м). Зная площадь чашки Петри, можно подсчитать количество клеток в 1 куб.м воздуха. Для этого число колоний, выросших в чашке Петри, относят к общей площади чашки, затем пересчитывают, сколько таких колоний поместилось бы на 100 см2 и далее – в 1 куб.м воздуха.11
3.3. Результаты исследования
Чтоб установить зависимость количества микрофлоры от соблюдения санитарно-гигиенических норм мы воспользовались методом Коха, установив чашки Петри в точках отбора на горизонтальной поверхности: на шкафу, подоконнике, на полу. Для определения общей микробной обсемененности чашки с мясопентанным агаром оставили открытыми на 15 минут в кабинете до занятия на 15 минут после занятий на тех же поверхностях. В журнале записали, на какое время выставлялись эти чашки. После экспозиции чашки закрыли и оставили на 5 суток при температуре 28 С. Это дало возможность развиться бактериальной флоре. На 5-е сутки инкубации осевшие бактерии образовали на среде колонии, кроме них выросли также грибы.
По количеству выросших колоний мы подсчитали микробное число воздуха, пользуясь правилом Омелянского, в соответствии с которым считают, что на поверхность питательной среды площадью 100. см2 в течение 5 минут оседает столько микроорганизмов, сколько их содержится в 10 л воздуха. Каждая микробная клетка дает начало одной колонии. Зная количество выросших колоний и время экспозиции, вычисляют количество микробов, содержащихся в 1 куб.м (1000 л) воздуха..
Сделав подсчеты, мы получили следующие результаты. ( см. Приложение )
Пробы воздуха | Точки отбора на горизонтальной поверхности | Микробное число |
Кабинет биологии Перед занятием | | |
Пол | 25 | |
Подоконник | 19 | |
Шкаф | 26 | |
После занятий | Пол | 35 |
« | Подоконник | 29 |
« | Шкаф | 30 |
Кроме подсчета колоний мы решили сделать описательную характеристику этих микроорганизмов. Описание колоний мы делали невооруженным глазом, перевернув чашку Петри дном вверх. Описание колоний делали по следующим признакам:
-форма колоний (округлая, овальная, чечевицеобразная, сплющенная);
- цвет колонии;
- характер края (ровный, волнистый, лучистый, зубчатый и пр.);
- блеск (блестящая, матовая, просвечивающаяся);
- центр колонии (имеется или отсутствует);
- поверхность (плоская, выпуклая, выгнутая, складчатая, зернистая).
Перед занятиями.
Точки отбора на горизонтальной поверхности | Описание колоний бактерий | |
Проба воздуха №1 | Проба воздуха №2 | |
П О Л | Большая расплывчатая колония (1 шт) | Небольшие плоские колонии розового цвета ( 15 шт) |
Небольшая конусообразная белая колония ( 8шт) | Расплывчатая колония (1 шт) | |
Плоская небольшая серая колония (6 шт) | Плоская серого цвета колония ( 3 шт) | |
Небольшие розовые конусообразные колонии ( 3 шт) | Маленькие желтые колонии ( 11 шт) | |
| Округлая конусообразная колония бежевого цвета ( 1 шт) | |
ПОДОКОННИК | Плоские колонии желтого цвета ( 4 шт) | Плоские желтые колонии (6 шт) |
Маленькие розовые конусообразные колонии ( 13 шт) | Плоские розовые колонии (11 шт) | |
Плоские серые колонии ( 3 шт) | Крупные серые плоские колонии (3 шт) | |
Конусообразные серые колонии (3 шт) | Белая плоская колония (1 шт) | |
Расплывчатая серая колония (1 шт) | Коричневая плоская колония ( 1 шт) | |
Серые колонии с внутренним слоем (3 шт) | Небольшие плоские серые колонии (3 шт) | |
Маленькие колонии телесного цвета ( 8 шт) | Красная плоская маленькая колония (13 шт) | |
| | Небольшая колония рыжего цвета (1 шт) |
ШКАФ | Расплывчатые колонии (2 шт) | Плоские желтые колонии (14 шт) |
Плоские колонии бежевого цвета (5 шт) | Коричневые колонии с лучистым краем (3 шт) | |
| Конусообразная коричневая колония (1 шт) | |
| Плоские белые колонии ( 3 шт) | |
| Большая серая колония (1 шт) | |
| Маленькие колонии телесного цвета (11 шт) | |
| Небольшие плоские колонии ( 3 шт) |
После занятий.
Точки отбора на горизонтальной поверхности | Описание колоний бактерий | |
Проба воздуха №1 | Проба воздуха №2 | |
ПОЛ | Небольшие розовые колонии (8 шт) | Маленькие желтые колонии (5 шт) |
Конусообразные розовые колонии (9 шт) | Маленькие розовые колонии (3 шт) | |
Белые маленькие колонии (4 шт) | Белые маленькие колонии (5 шт.) | |
Оранжевые маленькие колонии (3 шт.) | Большие серые расплывчатые колонии (2 шт.) | |
Маленькие телесные колонии (15 шт.) | Небольшие оранжевые колонии (2 шт.) | |
Большие расплывчатые телесного цвета колонии (2 шт. одна лучистая) | Небольшие белые колонии ( 4 шт) | |
Желтые маленькие колонии (3 шт) | | |
ПОДОКОННИК | Желтые маленькие колонии (7 шт.) | Розовая плоская маленькая колония (1 шт.) |
Розовые маленькие колонии (6 шт.) | Оранжевые маленькие колонии (4 шт.) | |
Белые маленькие колонии (5 шт.) | Небольшие телесного цвета колонии (5 шт.) | |
Большая расплывчатая колония (1 шт) | Большие расплывчатые колонии (2 шт.) | |
ШКАФ | Большие расплывчатые телесного цвета колонии (2 шт.) | Желтые маленькие колонии (5 шт.) |
Желтые конусообразные колонии (4 шт.) | Розовые конусообразные колонии ( 7 шт) | |
Белые маленькие колонии (6 шт.) | Телесные маленькие колонии (4 шт.) | |
Маленькие телесные6 колонии (4 шт) | | |
Розовая маленькая колония (1 шт.) | |
Кроме этого мы сравнили микробное число в пробе воздуха, взятого осенью с пробой воздуха, взятой летом.
Пробы воздуха | Сезон года | Микробное число |
Кабинет биологии А) чистый Б) загрязненный | Осень Осень | До 450 Более 525 |
А) чистый Б) загрязненный | лето лето | До 150 Более 225 |
Выяснили, что летом микробное число в воздухе в три раза меньше, по сравнению с осенним периодом, т.к. занятия в это время года в кабинете не проводятся.
Заключение
Атмосферный воздух городов постоянно обогащается разнообразной микрофлорой, поступающей в него из почвы, загрязненных улиц, водоемов. Источником воздушной патогенной флоры служат больные люди и животные. При кашле и чихании они наполняют воздух мельчайшими капельками, в которых находятся бактерии и вирусы. В организм человека за сутки попадает около 1 млрд. микробов. Повышенное микробное число в воздухе помещения указывает на присутствие в нем больного человека. Кроме того, микробиологическое загрязнение воздуха часто не зависит от наличия в помещении больных: наличие протечки, повышенная влажность, низкая освещённость, большое скопление людей создают условия для роста грибов и других микроорганизмов.
Проведенное исследование позволяет сделать следующие выводы:
-в чашках Петри выросли разнообразные по форме, цвету, поверхности колонии бактерий и грибов.
- количество колоний микробов в зависимости от чистоты помещения разное. После влажной уборки кабинета и мытья полов микробное число в пробе воздуха составило на полу-25, на подоконнике- 19, на шкафу -26, а после занятий микробное число в пробе воздуха на полу- 35, на подоконнике – 29, на шкафу -30.
-количество бактерий в воздухе летом уменьшается, т.к. в это время в школе не проходят учебные занятия
Борьба за чистоту воздуха является не только борьбой за чистоту в помещении, но и борьбой за здоровье детей.
Поэтому я считаю, что необходимо:
1.Ежедневно осуществлять влажную уборку помещений
2. Проветривать помещения в малые перемены при температуре +5 до 0 С –
3-7 минут, в большие перемены 20-30 минут, а при низких температурах от
-5 до -10 С, в малые перемены 1-3 минуты, в большие 10-15 минут.12
3.провести на классных часах, совместно с медицинским работником беседу о значении борьбы за чистоту воздуха.
4.Выпустить листовки с призывом соблюдения гигиенических правил в помещении, а также опасности заражения инфекционными заболеваниями.
5.Рекомендовать данные листовки в классные уголки.
« Нет ничего непознаваемого, есть еще много непознанного»,- говорил великий микробиолог Илья Ильич Мечников.
Я согласна с ним. Изучая количественный и качественный состав микрофлоры воздуха, я пришла к выводу, что микроорганизмы – это живая « лаборатория», в которой осуществляются сложные биохимические процессы. Выяснив это, мы решили продолжить наши исследования. В последующей работе я хочу выявить влияние фитонцидных свойств соков растений – цветков, плодов и ягод в отношении различных микроорганизмов воздуха.
Список использованной литературы
1.Бакулина Н.А., Краева Э.П. Микробиология. М. «Медицина», 1976.
2.Биргер М.О. Справочник по микробиологическим и вирусологическим методам исследования. М. « Медицина», 1982.
3. Блинкин С.А. « Вторжение в тайны неведимок». Изд-во « Просвещение» М. 1971.
4. Жвирблянская А.Ю.0, Бакушинская О.А. « Основы микробиологии, санитарии и гигиены в пищевой промышленности». М. « Легкая и пищевая промышленность» 1983.
5.Куликова И.Ю. «Микрофлора воздуха». Методическое пособие. Астрахань.2005.
6. g.ru/lib/children/ - 17k
7. n.allbest.ru/ecology/00019711_0.php - 144k
8. ссылка скрыта, ( картинки)
9. ссылка скрыта (картинки)
10. ссылка скрыта, (картинки)
11. ссылка скрыта ( картинки)
12. ссылка скрыта ( картинки)
13. ссылка скрыта ( картинки)
Приложение
Микрофлора воздуха перед занятиями


Пол


Подоконник

Шкаф
Микрофлора воздуха после занятий.


Пол


Подоконник

Шкаф.
1 Блинкин С.А. « Вторжение в тайны неведимок». Изд-во « Просвещение» М. 1971,с.29
2 g.ru/lib/children/ - 17k
9 Куликова И.Ю. «Микрофлора воздуха»: Методическое пособие для студентов специальности «Микробиология» АГТУ, Астрахань,2005 г. стр.8
10 Куликова И.Ю. «Микрофлора воздуха»: Методическое пособие для студентов специальности «Микробиология» АГТУ, Астрахань,2005 г. стр.12
11 Куликова И.Ю. «Микрофлора воздуха»: Методическое пособие для студентов специальности «Микробиология» АГТУ, Астрахань,2005 г. стр.16
12 . n.allbest.ru/ecology/00019711_0.php - 144k